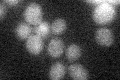
YBR290W
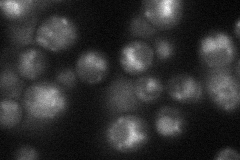
YBR290W

View description
Heavy metal ion homeostasis protein, facilitates trafficking of Smf1p and Smf2p metal transporters to the vacuole where they are degraded, controls metal ion transport, prevents metal hyperaccumulation, functions in copper detoxification
Localization:
Intensity:
Fold change:
Significance:
-
C’ GFP library in SD
below threshold14.59 -
N' NOP1pr-GFP in SD
punctate,vacuole33.6177 -
N' TEF2pr-mCherry in SD

vacuole41.5513 -
N' NATIVEpr-GFP in SD

ambiguous25.6479 -
N' TEF2pr-VC and Cyto-VN in SD

below threshold25.4844 -
C’ GFP library in SD+DTT

cytosol14.861.01No -
C’ GFP library in SD+H2O2

cytosol13.570.92No -
C’ GFP library in Starvation Media

cytosol18.751.28No -
C’ GFP library on the background of Pup2-DaMP

below threshold -
C’ GFP library on the background of CCT mutant

below threshold13.24030.906912No
